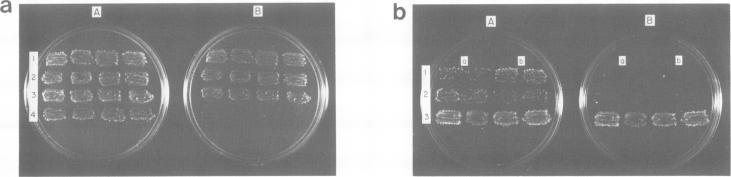
https://cdn.ncbi.nlm.nih.gov/pmc/blobs/eac6/401381/1a6ce593dbe1/emboj00134-0257-a.jpg

在酿酒酵母中干扰RAS效应器功能的H-ras突变体。
Mutants of H-ras that interfere with RAS effector function in Saccharomyces cerevisiae.
作者信息
Michaeli T, Field J, Ballester R, O'Neill K, Wigler M
机构信息
Cold Spring Harbor Laboratory, NY 11724.
出版信息
EMBO J. 1989 Oct;8(10):3039-44. doi: 10.1002/j.1460-2075.1989.tb08454.x.
We report a class of interfering mutants of the human H-ras gene capable of inhibiting phenotypes arising from the expression of the activated RAS2 gene, RAS2val19, in the yeast Saccharomyces cerevisiae. All these mutants encode unprocessed H-ras proteins that remain in the cytoplasm. One of the mutants, H-rasarg186, was examined in detail. H-rasarg186 protein is a competitive inhibitor of RAS2val19 protein. It does not interfere with processing and membrane localization of RAS2val19, nor does it appear to compete with RAS protein for its proposed regulator, the CDC25 protein. By several criteria the RAS2val19 adenylate cyclase interaction is unaffected by H-rasarg186. We infer from our results that H-rasarg186 protein interferes with an alternative function of RAS2val19.
我们报告了一类人类H-ras基因的干扰突变体,它们能够抑制在酿酒酵母中由活化的RAS2基因RAS2val19表达所产生的表型。所有这些突变体编码的未加工H-ras蛋白都保留在细胞质中。其中一个突变体H-rasarg186被详细研究。H-rasarg186蛋白是RAS2val19蛋白的竞争性抑制剂。它不干扰RAS2val19的加工和膜定位,也似乎不与RAS蛋白竞争其假定的调节因子CDC25蛋白。根据几个标准,RAS2val19与腺苷酸环化酶的相互作用不受H-rasarg186的影响。我们从结果中推断,H-rasarg186蛋白干扰了RAS2val19的另一种功能。